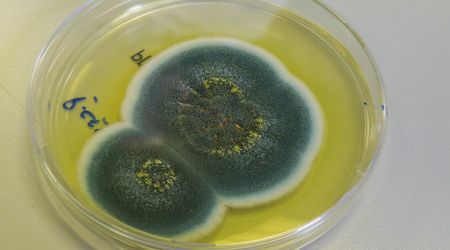

Aclyy
@112-acil
Join Date:
January 01, 2020
Publications:
2

Adem Elması
Adem Elması, boğazımızda yer alan gırtlağı çevreleyen kıkırdaktır. Ergenlik döneminde özellikle erkeklerde gırtlağın yavaş yavaş boğazdan aşağıya doğru yer deği
Views:
440
İnsanlığın En Büyük Buluşlarından Biri:Penisilin
Penisilin, bakterilerden kaynaklı enfeksiyonlara karşı kullanılan ve geniş yelpazede bakterilere saldırarak üremelerini ve gelişmelerini engelleyen antibakteriy
Views:
65
1/1